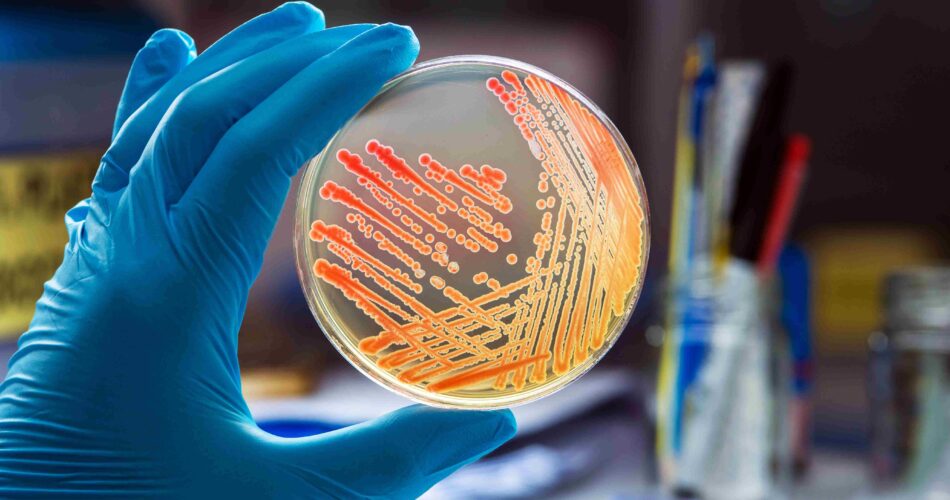
Как лечить инфекцию при беременности

- Causes of Infections During Pregnancy
- The Danger of Developing Infections During Pregnancy
- Symptoms of Infections During Pregnancy
- Toxoplasmosis and Rubella – Symptoms
- Cytomegalovirus and herpes – how to recognize
- Complications and Consequences
- Consequences of Other Infections
- Diagnosis of Infections During Pregnancy
- Treatment of Infections During Pregnancy
The fact that pregnancy is the most responsible stage in a woman’s life is an unassailable axiom. Maintaining health and preventing infections during pregnancy is one of the main tasks that face the expectant mother and the doctor responsible for the pregnancy.
Continuous monitoring of well-being and conducting laboratory tests to create an objective picture of the pregnant woman’s health is very important to prevent or promptly start treatment if illness does occur. This is because infections during pregnancy can have the most serious consequences, including for the developing fetus, in the form of dangerous complications. Aside from the harm to the pregnant woman’s health, these can result in birth defects and even pose a threat to the life of her future child.

Causes of Infections During Pregnancy
The causes of infections during pregnancy can vary greatly, just like the infections themselves. These can include sexually transmitted infections as well as those contracted through contact with infected individuals. During this period, the risk of contracting such infections increases significantly. This occurs due to disruptions in vaginal flora, hormonal imbalances, and physiological peculiarities of the immune system during pregnancy.
An example is thrush – it occurs 2–3 times more often in pregnant women than in non-pregnant women. Similarly, one in four is diagnosed with bacterial vaginosis. This also applies to other infectious diseases that non-pregnant women might not contract. However, the overall reduction in immunity also contributes to their development.
The Danger of Developing Infections During Pregnancy
Although any infections during pregnancy are undesirable, the most dangerous are those included in the so-called TORCH complex. This special term refers to the following infectious diseases – toxoplasmosis, rubella, cytomegalovirus, herpes. However, these ailments do not limit the dangers for pregnant women. There are other diseases, such as enterovirus, hepatitis B and C, chlamydia, syphilis, gonorrhea, chickenpox, listeriosis, HIV.
Some of these diseases may pass without consequences for all other categories of patients, but for a pregnant woman and her fetus, they are extremely dangerous. They are especially undesirable in the 1st trimester, as they generally lead to:
- severe central nervous system defects;
- congenital deformities;
- miscarriages;
- stillbirth.
Diagnosis of TORCH infections in the first trimester is a direct indication for pregnancy termination.
Symptoms of Infections During Pregnancy
To recognize the most dangerous infections during pregnancy, it is important to be aware of their main symptoms. In some cases, the disease may be asymptomatic after infection; however, by paying careful attention to her health, a mother-to-be can often hear warning “bells” and promptly consult a doctor for appropriate treatment.
Although infections in the second trimester pose less risk for the baby compared to early pregnancy infections since the main systems and organs have already formed, expectant mothers still need to be aware of what illness a particular symptom or combination of symptoms might indicate. Undoubtedly, the final word in diagnosis will be given by the doctor overseeing the pregnancy. It’s important not only to be aware of the symptoms of the most dangerous infectious diseases, but also to know how to reduce the risk of contracting them.
Toxoplasmosis and Rubella – Symptoms
Two very dangerous infections during pregnancy are toxoplasmosis and rubella. These diseases, which are almost harmless in usual situations, become a serious problem during pregnancy. Toxoplasmosis usually has no symptoms, but when the disease becomes acute or chronic, it can manifest through an enlarged spleen and liver, swollen lymph nodes in the groin and underarms, chills, fever, and weakness. The source of infection is cats, raw or undercooked meat. For prevention, it is advisable to avoid contact with animals and wash vegetables, greens, and fruits with soap before consumption.
Rubella is an exceptionally dangerous disease both in the 1st and 2nd trimester and even in the last weeks of pregnancy. Its symptoms include a fine pink rash all over the body and a rise in temperature up to 38°C. The only way to protect against infection is timely vaccination when planning a pregnancy.

Cytomegalovirus and herpes – how to recognize
Another formidable infection is cytomegalovirus (CMV). Women often mistake its symptoms for a trivial cold, which include weakness, increased body temperature, inflammation and enlargement of salivary glands, headaches, rapid fatigue, runny nose, and sometimes tonsillitis. The infection can have catastrophic consequences and complications for the fetus. It is transmitted through sexual contact, blood, saliva, breast milk, and household items (such as towels or washcloths). Prevention involves maintaining personal hygiene and using condoms.
Chronic infection is not as dangerous if during pregnancy it merely transitions into an acute phase; primary infection is more dangerous. The herpes virus can live in the body for years, manifesting during colds with a slight fever, rashes on the lips, nasal mucosa, genitals, and skin. The only way to avoid primary infection is to generally strengthen the immune system.
Complications and Consequences
Knowing the symptoms of various infections during pregnancy, it is important to understand the seriousness of the diseases they cause. For instance, toxoplasmosis infection in the 1st trimester can lead to fetal death and miscarriage; in the 2nd and 3rd trimesters, it can cause brain damage, eye issues in the baby, and severe developmental defects. Rubella infection also has dire consequences – such infection is an indication for termination of pregnancy.
It has a negative impact on fetal development and manifests in meningitis, brain reduction, heart defects, changes in eyeballs, congenital cataracts, encephalitis, deafness. Early infection with CMV can result in spontaneous miscarriage, fetal developmental abnormalities, and, at later stages, congenital cytomegalovirus infection, polyhydramnios, and premature birth. Developing herpes leads to fetal death, miscarriage, liver damage, brain damage, and congenital deformities.
Consequences of Other Infections
Unfortunately, not only does the TORCH complex pose serious threats to the development of the future child. Other infections during pregnancy are equally dangerous. For example, chickenpox, which is not included in the TORCH list, can cause significant harm to both the future mother and the baby. For a woman, being infected is even more dangerous – she may develop pneumonia due to immune deficiency, which can be fatal. For the fetus, the virus is also hazardous and can lead to intrauterine death or developmental defects.
Bacterial vaginosis is not so safe either – it can lead to premature birth. Gonorrhea is also dangerous, causing miscarriage, premature birth, fetal developmental defects, and after birth, the development of sepsis, meningitis, and dermatological problems. Group B streptococcus can be transmitted from mother to baby and lead to negative consequences, up to infant death.
Diagnosis of Infections During Pregnancy
Diagnosing the presence of various infections during pregnancy is possible by undergoing the necessary tests during the initial visit to the gynecologist after confirming conception and registering for prenatal care. The presence or absence of infections related to the TORCH complex is determined through blood tests for IgM and IgG antibodies to the pathogens and by determining their concentration.
If the number of antibodies to a specific type of infection is too high or shows an increase over time, it indicates the activity of a pathological process. The doctor who orders the test analyzes the results and determines the timing of a repeat test if they appear questionable. In all other cases, a diagnosis is made and a treatment plan for the pregnant woman is developed.

Treatment of Infections During Pregnancy
How to treat an infection during pregnancy depends on the specific infection diagnosed from the blood tests taken by the expectant mother. The further treatment strategy is developed by the attending healthcare provider in collaboration with the expectant mother, taking into account all risks to the fetus and the effects of prescribed medications. In some cases, amniocentesis – an invasive diagnostic procedure – may be required to determine its infection.
Thus, for the treatment of cytomegalovirus infection during pregnancy, acyclovir and valganciclovir are usually prescribed. In the case of toxoplasmosis, spiramycin and sulfonamides may be prescribed, although they pose potential toxic risks to the fetus. However, based on the cause, symptoms, and disease progression, the treatment plan is selected solely by the attending physician – often an obstetrician-gynecologist in collaboration with an infectious disease specialist.



Download the app and get 7 days free use
 eng
eng rus
rus deu
deu spa
spa fra
fra ita
ita por
por srp
srp tur
tur ukr
ukr por
por bos
bos